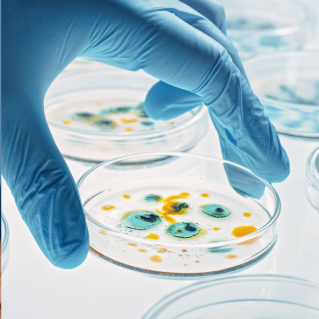

The 3R Gut Reset Program
Remove. Replenish. Revive.

Advanced Gut Health, Delivered Simply.
The 3R (Remove, Replenish, Revive) Gut Reset Program features three industry-leading and expert-formulated supplements that work synergistically to help restore gut health. Start with a GI Spotlight test, used by thousands of practitioners to assess GI health and support energy,mood, sleep, skin, and healthy appetite. The 3R Gut Reset Program is the three-step solution to support your healthiest, happiest, most energetic self.

Step 1:
Remove*
First, IgGI Shield™ helps eliminate harmful toxins with Immunolin©, the highest concentration immunoglobulin, while N-acetyl-D-glucosamine (NAG), a next-generation GI compound, works with the body’s natural processes to help fortify the mucus layer, a critical barrier for gut integrity. * * These statements have not been evaluated by the Food and Drug Administration. This product is not intended to diagnose, treat, cure, or prevent any disease.

Step 2:
Replenish*
First, IgGI Shield™ helps eliminate harmful toxins with Immunolin©, the highest concentration immunoglobulin, while N-acetyl-D-glucosamine (NAG), a next-generation GI compound, works with the body’s natural processes to help fortify the mucus layer, a critical barrier for gut integrity. * * These statements have not been evaluated by the Food and Drug Administration. This product is not intended to diagnose, treat, cure, or prevent any disease.

Step 3:
Revive*
First, IgGI Shield™ helps eliminate harmful toxins with Immunolin©, the highest concentration immunoglobulin, while N-acetyl-D-glucosamine (NAG), a next-generation GI compound, works with the body’s natural processes to help fortify the mucus layer, a critical barrier for gut integrity. * * These statements have not been evaluated by the Food and Drug Administration. This product is not intended to diagnose, treat, cure, or prevent any disease.
Like the other 30+ industry-leading GI products from Designs for Health, the 3R Gut Reset Program features the most advanced ingredients on the market, including the highest concentration immunoglobulin, cutting-edge NAG, the most-researched probiotic strains, and more.*

- Test GI biomarkers for targeted support that starts in the gut and benefits overall health.*
- Featuring NAG, a cornerstone of next generation gut support.* NAG helps support the mucus layer and a resilient GI barrier.*
- Featuring the 10 most researched probiotic strains for the top 5 most common GI complaints.*
- Science-backed ingredients shown to help remove toxins, replenish the microbiome, and revive the GI barrier.*
* These statements have not been evaluated by the Food and Drug Administration. This product is not intended to diagnose, treat, cure, or prevent any disease.

DRIVEN FROM WITHIN
The 3R Gut Reset Program is the three-step solution to support your healthiest, happiest, most energetic self
Order Now
The Designs for Health® Difference
Trusted nutrition research experts since 1989 with a strong history of regulatory oversight and responsible manufacturing, Designs for Health has introduced the most cutting-edge GI portfolio in the industry.